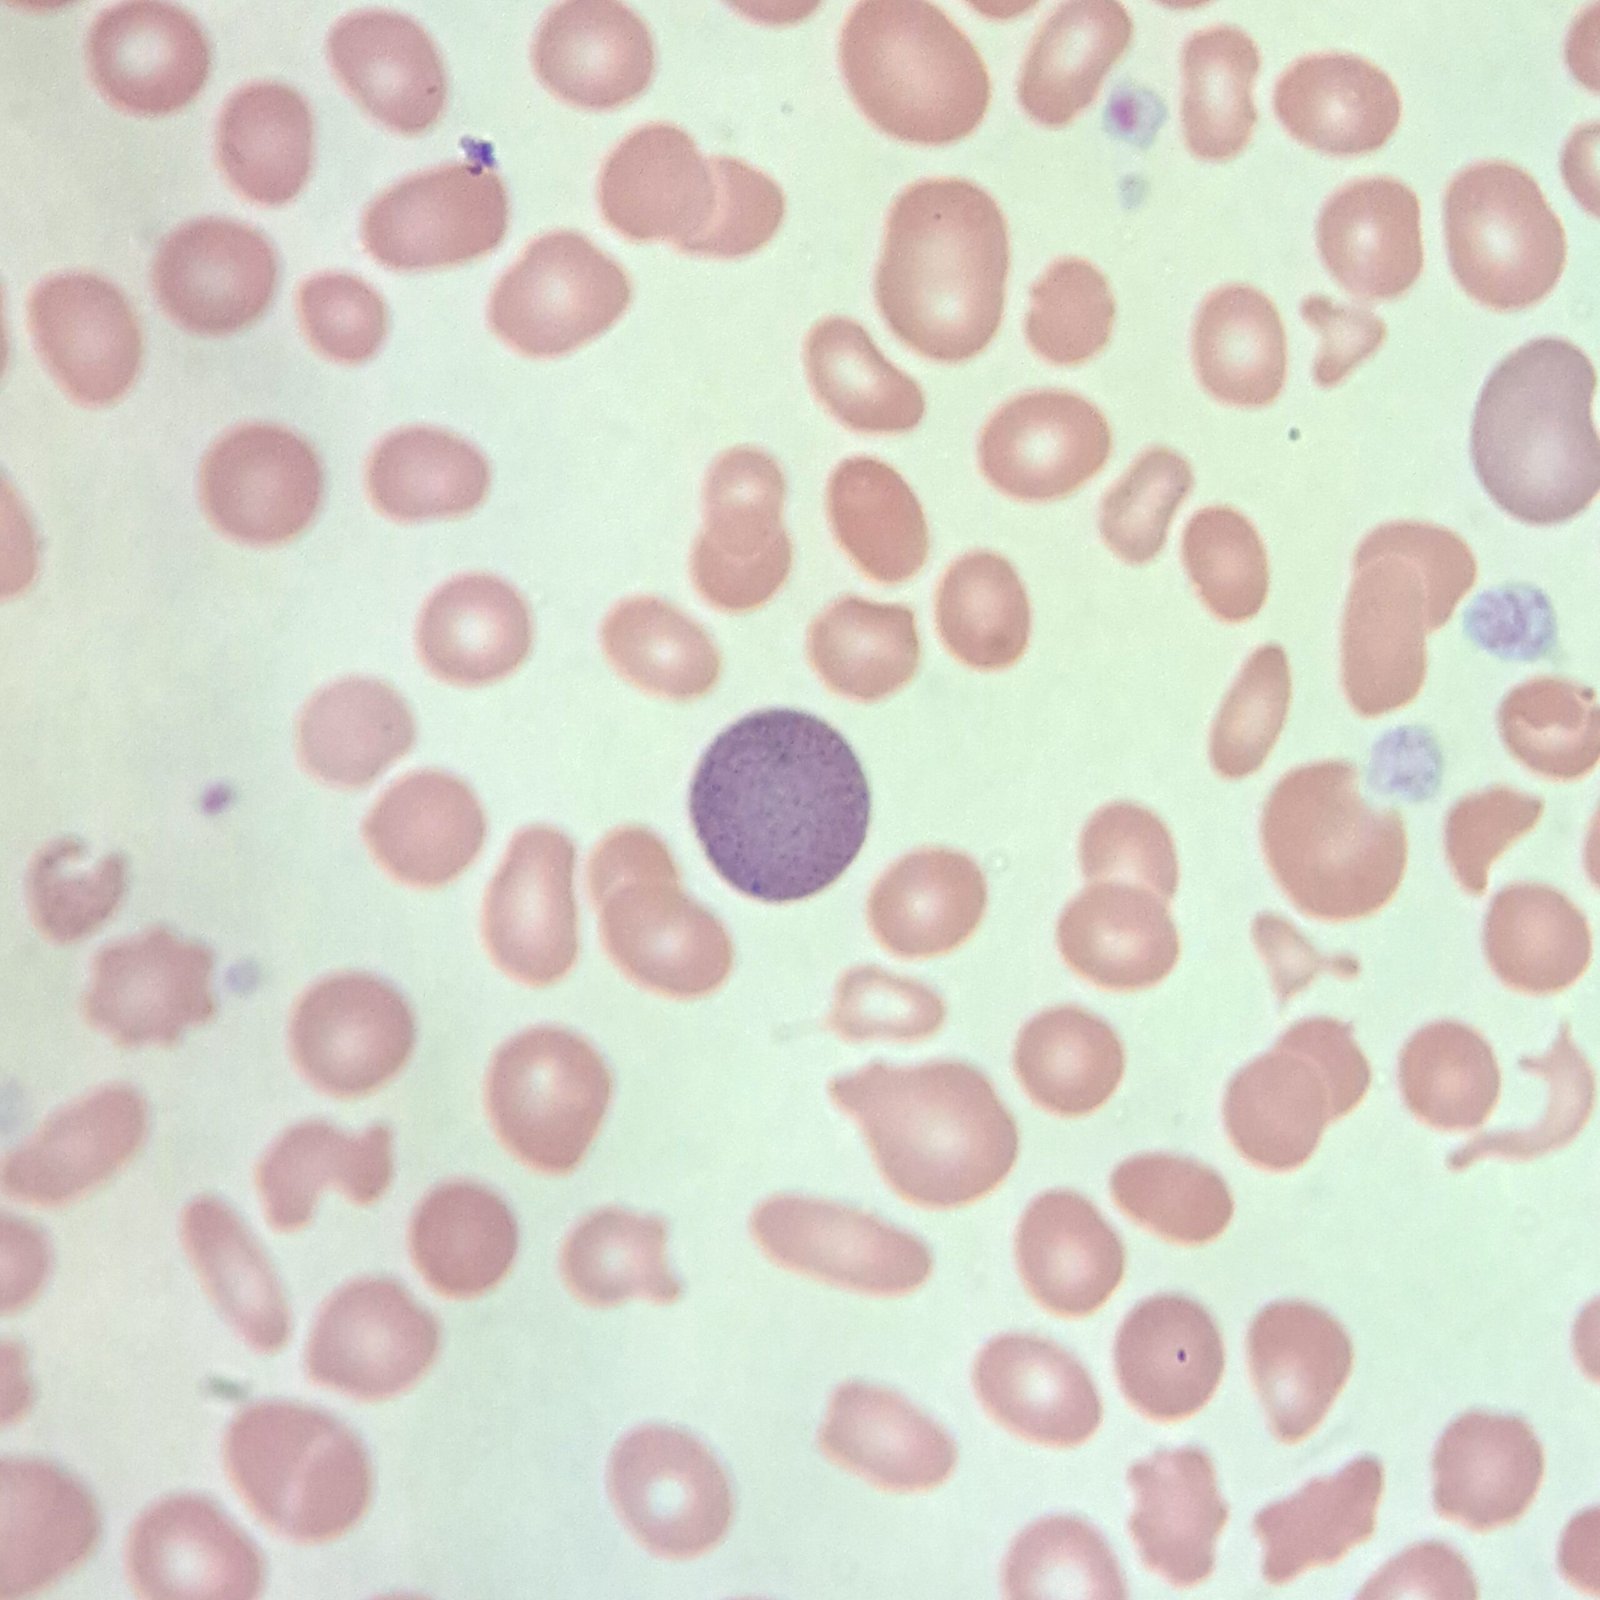
Fine Basophilic Stippling, red blood cell inclusions
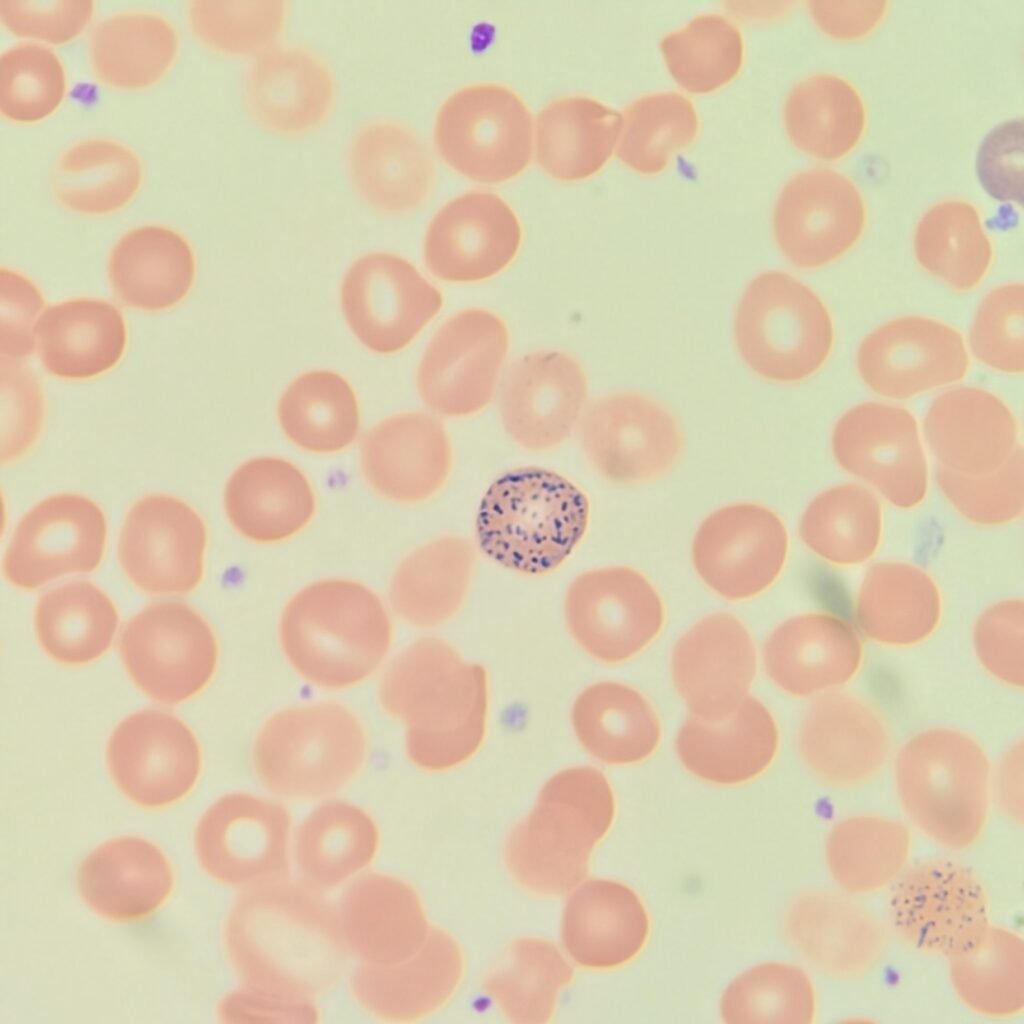
Coarse Basophilic Stippling, red blood cell inclusions

Basophilic stippling refers to the presence of ribosomal aggregates in red blood cells. These aggregates appear as dark blue granules dispersed throughout the erythrocyte. This coarse stippling is seen in lead poisoning, thalassemia, sideroblastic anemia, megaloblastic anemias, and defective heme synthesis.
Fine basophilic stippling is usually not reported, as it is the result of immature polychromatophilic cells and not indicative of defective heme synthesis.
Coarse Stippling
Coarse stippling is readily apparent with evenly dispersed large granules.

Fine Stippling
Fine stippling appears as evenly distributed purple dust and is hard to see in a cell. Fine stippling is seen in polychromatic cells from residual RNA and is typically not clinically significant.
Lookalikes
Pappenheimer bodies are another red blood cell inclusion that may be mistaken for stippling. Pappenheimer bodies, however, are fewer in number and clustered on the periphery instead of being evenly distributed among.
Pappenheimer Bodies

Coarse Stippling Gallery

Fine Stippling Gallery







